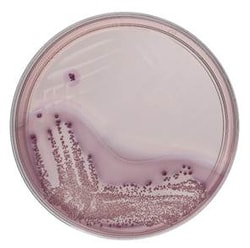
Thermo Scientific Violet Red Bile Glucose Agar (ISO) 10 Plates | Buy Online | Thermo Scientific&trade; | Fisher Scientific

missing translation for 'onlineSavingsMsg'
Learn More
Learn More
Thermo Scientific™ Violet Red Bile Glucose Agar (ISO)
Click to view available options
Quantity:
10 Plates
Unit Size:
Pack of 10
Description
Enhance the detection of glucose-fermenting bacteria with Violet Red Bile Glucose Agar (ISO), designed for selective isolation.

Specifications
Specifications
| Color | Transparent |
| Content And Storage | 2°C to 12°C |
| Format | 90 mm |
| Manufacturing Origin | Germany |
| Product Type | Agar Plate |
| Fill Volume | 17 mL |
| Quantity | 10 Plates |
Product Content Correction
Your input is important to us. Please complete this form to provide feedback related to the content on this product.
Product Title
Spot an opportunity for improvement?Share a Content Correction